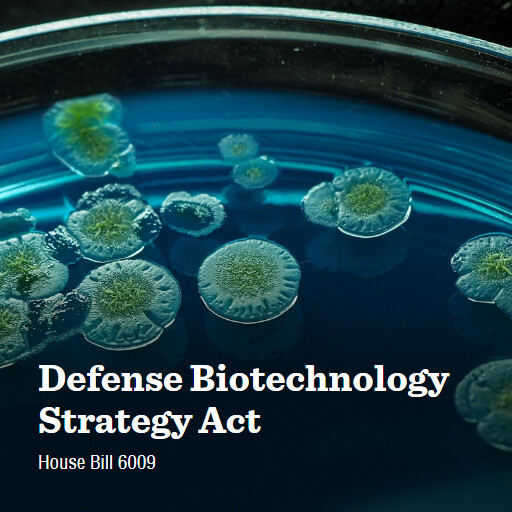
H.R.6009 119 Defense Biotechnology Strategy Act

House Bill 6009
119th Congress(2025-2026)
Defense Biotechnology Strategy Act
Introduced

Introduced in House on Nov 10, 2025
Origin Chamber
House
Type
Bill
Bill
The primary form of legislative measure used to propose law. Depending on the chamber of origin, bills begin with a designation of either H.R. or S. Joint resolution is another form of legislative measure used to propose law.
Bill Number
6009
Congress
119
Policy Area
Armed Forces and National Security
Armed Forces and National Security
Primary focus of measure is military operations and spending, facilities, procurement and weapons, personnel, intelligence; strategic materials; war and emergency powers; veterans’ issues. Measures concerning alliances and collective security, arms sales and military assistance, or arms control may fall under International Affairs policy area.
No House votes have been held for this bill.
Summary
Unavailable
November 10, 2025
Sort by most recent
11/10/2025
Referred to the Committee on Armed Services, and in addition to the Committee on Foreign Affairs, for a period to be subsequently determined by the Speaker, in each case for consideration of such provisions as fall within the jurisdiction of the committee concerned.
11/10/2025
Introduced in House
Graphics
Bill graphics are created by our staff using freely licensed images. You are welcome to share these graphics elsewhere. To view our full catalog of bill graphics, visit the graphics page.
Since bill titles can change, some graphic titles may differ from their most recent bill title.
Public Record
Record Updated
Jan 8, 2026 9:06:33 AM